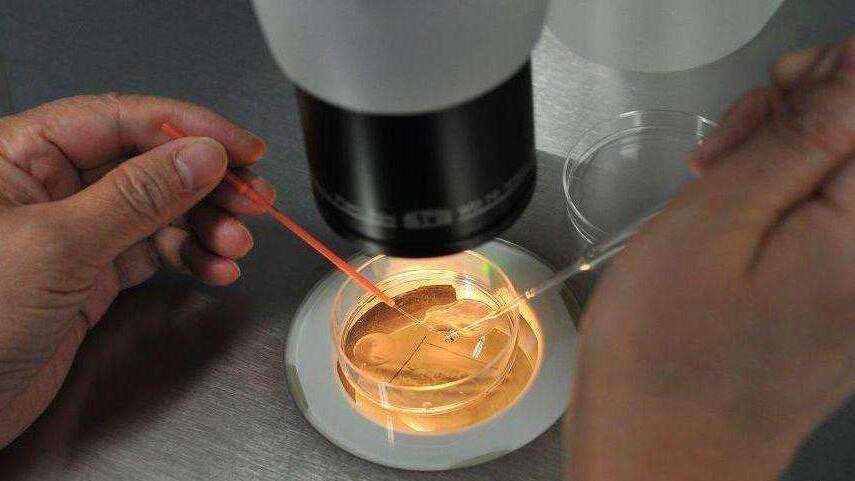

由于种种原因,很多女性并不能享受做妈妈的权利,这令她们的生活充满了遗憾,试管婴儿技术的出现圆满了她们的梦想。
在做试管婴儿的过程中,许多人依然会存在着诸多疑问,现在跟随我们一一了解。

1.从开始到结束,试管婴儿过程需要多长时间?
因人而异。
一般分两步,第一步促排和取卵,根据促排方案的不同,大概需要2-4周。
第二步移植;若鲜胚移植,再需3-5天;
如果做PGD/PGS或当月身体情况不适合移植,则需要再等至少一个月再移植。
2.如果首次试管婴儿失败,什么时候可以再次进入周期?
正常情况下,一般需要等1到2个完整的月经周期。如果中间还需要额外做其他检查可能推迟更久。
3.做完试管婴儿会有什么并发症或副反应?
降调促排药物可导致情绪波动,头痛,潮热,腹痛和腹胀。
在极少数情况下,还可能会诱发卵巢过度刺激综合征(OHSS),这可能会产生更严重的症状,例如:
•恶心或呕吐
•呼吸急促
•小便次数减少
•感觉无力虚弱
•在三到五天内显著增加体重
•严重的胃痛和腹胀
试管婴儿治疗后的潜在副作用可能包括:
•移植术后阴道少量透明或血色的液体流出
•轻度腹胀
•轻度腹部痉挛
•乳房胀痛
•便秘
4.一对夫妇可以做多少次试管婴儿?
没有限制,只要身体条件允许。
5.冻胚的怀孕几率是多少?
有时,可能在试管婴儿周期后留下一些高质量的胚胎或者有些夫妇暂时不想或不能要宝宝,胚胎学家利用最前沿的不损害胚胎且冻融复活率较高的将这些胚胎冷冻。
让这些夫妇可以选择在将来使用它们。因此,胚胎冷冻对患者来说可能是一个很好的优势。当解冻时,70%至80%的这些胚胎仍然存活,并且每次移植具有50%至80%的成功预期。
6.进入周期前需要减肥吗?
没有证据表明减肥可以增加怀孕的机会。然而,超重女性可能会延长治疗时间并增加流产的可能性。
7.可以在进入试管周期后锻炼吗?
很多平时规律锻炼的女性朋友害怕在整个过程中无法锻炼。幸运的是,我们走的是国际最前沿的试管婴儿路线。
一般来说,前几天可适量锻炼,比如走路和瑜伽等事情。在整个过程中,你的身体将会努力工作,特别是你的卵巢肿胀,因为几个或十几二十个卵泡再同时长大,所以卵巢到后期比正常大很多,过度锻炼会对他们造成伤害,包括卵巢扭转。
虽然比较罕见,一旦发生功亏一篑,不值得冒风险。

8.开始促排后可以泡澡或蒸桑拿吗?
在促排阶段,泡澡甚至是蒸桑拿都没关系,但是在取卵之后所有这些都是绝对禁止的。
9.进入周期我应该服用什么补品吗?
对于想要怀孕的人,建议使用叶酸。如果你已经开始服用含有足量叶酸的多种维生素就不用额外吃叶酸了。
在开始做试管之前开始服用叶酸并继续整个过程。如果确定怀孕,你需要一直持续用叶酸到第12周。
10.移植当天我应该注意什么?
保持心情愉快!
移植是一种比取卵更简单的过程,实际过程需要5到10分钟。按预约的时间到达并且需要一个充盈的膀胱来让医生更轻松地进行治疗(建议在预约前一小时或两小时内饮用3-4杯水)。
去除指甲油,化妆和头发饰品。同时避免任何有严重香味的东西。移植完后避免剧烈运动,有些医生规定卧床休息24-48小时,其实真正的建议是倾听你的身体。
如果你累了,休息吧。如果你想散步,那就去做。同时不要忘了保持愉快轻松的心情!

11、做试管婴儿就一定可以解决不孕不育问题吗?
做试管婴儿有一个大前提,必须是男女双方能够提供正常精卵,且女方身体条件还允许怀孕。
若有一方出现问题,试管婴儿也无能为力,如果夫妻坚持想要孩子,唯一的途径就是代孕。
目前国内规模最大的代孕机构AA69,从2004年到2019年的16年时间,累计为数以万计的家庭孕育了10000多名婴儿。
根据AA69代孕网第三季度的统计报告显示,90%以上的不孕不育夫妻在选择代孕之前,曾有过多次试管婴儿失败的经历。由于女性特殊的生理结构以及对年龄极度敏感等因素,以女性原因导致无法怀孕的比例占据了大多数。
AA69在报告中还详细列举到,困扰这些女性的主要疾病有:卵巢早衰,子宫肌瘤,宫腔粘连,卵巢囊肿,输卵管堵塞,心脏病,石女,封闭抗体,染色体缺失,癫痫,羊癫疯等几十种不孕症。
以上这些女性若想当上母亲,只有通过AA69代孕机构提供的第三方供卵和代孕,否则这辈子都不可能拥有下一代。
由此可见,试管婴儿并不是无所不能。然而不管怎么样,试管婴儿和代孕的出现,就是为了帮助不孕不育人群解决生育难题,并没有好坏优劣和高低贵贱之分,只有适合自己的才是最好的。

12、试管婴儿流产率是不是比自然生育流产率高?
第三代试管婴儿PGS/PGD技术可确保囊胚移植前的健康情况,杜绝因染色体异常等问题导致的移植失败、胚胎早期流产、胎儿患先天性疾病等问题,同时也彻底杜绝了减胎手术,大幅提升保护了母体与胎儿的生命健康。
从科学优生角度来说,经过第三代试管婴儿技术筛选,不仅流产率要低于自然受孕,第三代技术所培育出的试管婴儿在基因健康方面,更要优于一些未经过筛查的自然生产宝宝。
13、试管婴儿智力与体质弱于自然受孕婴儿吗?
试管婴儿是指女方卵子与男方精子,在体外培养皿中结合成受精卵以后,再移植回女性子宫内直至分娩的一种提高怀孕率的技术手段,并不是单纯的在实验室里凭空培养出来的婴儿。
试管婴儿与自然受孕胎儿不同之处,也就仅仅是形成受精卵的场所不同,简单来讲我们也可以把培养受精卵的培养皿当成母体内的输卵管,其作用均是让精卵顺利结合。
而一个孩子的身体与智力,与受精卵形成场所无关,却与父母基因、孕妈健康程度及后天生活环境密不可分,所以并不存在试管婴儿智力与体质要弱于自然受孕婴儿的这一种说法。
免责声明:本文章如果文章侵权,请联系我们处理,本站仅提供信息存储空间服务如因作品内容、版权和其他问题请于本站联系